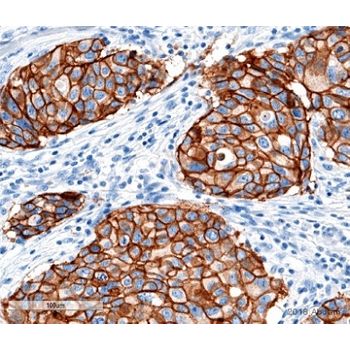

Helping to accelerate the next breakthrough in drug discovery, diagnostics and basic research.
Abcam
Anti-ErbB2 / HER2 antibody [SP3] | Abcam
Rabbit Recombinant Monoclonal ErbB2 / HER2 antibody. Suitable for IHC-P and reacts with Human samples. Cited in 8 publications.
More Scientific Products from Abcam
Opens in a new window
Opens an external site
Opens an external site in a new window




![Anti-PRAME antibody [EPR20330]](https://d3bkbkx82g74b8.cloudfront.net/eyJidWNrZXQiOiJsYWJyb290cy1pbWFnZXMiLCJrZXkiOiJjb21wYW55X3Byb2R1Y3RfcHJvZmlsZV9pbWFnZV9mMzEwNTY4MGY1NmVmZjU3ZjZhMWRkZTU2M2Q4YjBmODZjMDJkNDE4XzMwMDA3MTg1ODEyLmpwZyIsImVkaXRzIjp7InRvRm9ybWF0IjoianBnIiwicmVzaXplIjp7IndpZHRoIjozMDAsImhlaWdodCI6MzAwLCJmaXQiOiJjb250YWluIiwicG9zaXRpb24iOiJjZW50ZXIiLCJiYWNrZ3JvdW5kIjoiI2ZmZiJ9LCJmbGF0dGVuIjp7ImJhY2tncm91bmQiOiIjZmZmIn19fQ==)

](https://d3bkbkx82g74b8.cloudfront.net/eyJidWNrZXQiOiJsYWJyb290cy1pbWFnZXMiLCJrZXkiOiJjb21wYW55X3Byb2R1Y3RfcHJvZmlsZV9pbWFnZV85NzllY2VhY2YwNjZjMmYxYTMyMjk3NTE3Yzg0Y2ZjYzc2NzQwNmIwXzY1MTUwNzE2Njg5LnBuZyIsImVkaXRzIjp7InRvRm9ybWF0IjoianBnIiwicmVzaXplIjp7IndpZHRoIjozMDAsImhlaWdodCI6MzAwLCJmaXQiOiJjb250YWluIiwicG9zaXRpb24iOiJjZW50ZXIiLCJiYWNrZ3JvdW5kIjoiI2ZmZiJ9LCJmbGF0dGVuIjp7ImJhY2tncm91bmQiOiIjZmZmIn19fQ==)

![Anti-CD31 antibody [JC/70A]](https://d3bkbkx82g74b8.cloudfront.net/eyJidWNrZXQiOiJsYWJyb290cy1pbWFnZXMiLCJrZXkiOiJjb21wYW55X3Byb2R1Y3RfcHJvZmlsZV9pbWFnZV82NjE2YzY4YTE5MTE0MTc2Yjg1MDRjZjdmMWVhMTk0ZTM1YzcxYzRkXzYzNzEzNzMyNjg3LmpwZyIsImVkaXRzIjp7InRvRm9ybWF0IjoianBnIiwicmVzaXplIjp7IndpZHRoIjozMDAsImhlaWdodCI6MzAwLCJmaXQiOiJjb250YWluIiwicG9zaXRpb24iOiJjZW50ZXIiLCJiYWNrZ3JvdW5kIjoiI2ZmZiJ9LCJmbGF0dGVuIjp7ImJhY2tncm91bmQiOiIjZmZmIn19fQ==)
![Anti-TGF beta 1 antibody [EPR21143]](https://d3bkbkx82g74b8.cloudfront.net/eyJidWNrZXQiOiJsYWJyb290cy1pbWFnZXMiLCJrZXkiOiJjb21wYW55X3Byb2R1Y3RfcHJvZmlsZV9pbWFnZV9hOTBkN2Q0ZWY2Y2U3NjEwZjgzMDc5OWFmNzg0NDIzNjFhNDQwODBkXzkzOTY5ODMzNDU2LmpwZyIsImVkaXRzIjp7InRvRm9ybWF0IjoianBnIiwicmVzaXplIjp7IndpZHRoIjozMDAsImhlaWdodCI6MzAwLCJmaXQiOiJjb250YWluIiwicG9zaXRpb24iOiJjZW50ZXIiLCJiYWNrZ3JvdW5kIjoiI2ZmZiJ9LCJmbGF0dGVuIjp7ImJhY2tncm91bmQiOiIjZmZmIn19fQ==)

![Anti-CD4 antibody [EPR6855] - BSA and Azide free](https://d3bkbkx82g74b8.cloudfront.net/eyJidWNrZXQiOiJsYWJyb290cy1pbWFnZXMiLCJrZXkiOiJjb21wYW55X3Byb2R1Y3RfcHJvZmlsZV9pbWFnZV8zMGVjYjRkNDUwNDRiNTYwODdlODVjOTNlMGUyZTk0MDE3NzkyMzU2XzY3ODM1MzE4NDk1LmpwZyIsImVkaXRzIjp7InRvRm9ybWF0IjoianBnIiwicmVzaXplIjp7IndpZHRoIjozMDAsImhlaWdodCI6MzAwLCJmaXQiOiJjb250YWluIiwicG9zaXRpb24iOiJjZW50ZXIiLCJiYWNrZ3JvdW5kIjoiI2ZmZiJ9LCJmbGF0dGVuIjp7ImJhY2tncm91bmQiOiIjZmZmIn19fQ==)

![Anti-STAT6 antibody [YE361]](https://d3bkbkx82g74b8.cloudfront.net/eyJidWNrZXQiOiJsYWJyb290cy1pbWFnZXMiLCJrZXkiOiJjb21wYW55X3Byb2R1Y3RfcHJvZmlsZV9pbWFnZV81MmMyZWFlOGEzNGEwOTFmNTUzYmE5ZWQwNDY2Yzk2MTViZWYyYTE4XzM5OTQ5NDE5Mi5qcGciLCJlZGl0cyI6eyJ0b0Zvcm1hdCI6ImpwZyIsInJlc2l6ZSI6eyJ3aWR0aCI6MzAwLCJoZWlnaHQiOjMwMCwiZml0IjoiY29udGFpbiIsInBvc2l0aW9uIjoiY2VudGVyIiwiYmFja2dyb3VuZCI6IiNmZmYifSwiZmxhdHRlbiI6eyJiYWNrZ3JvdW5kIjoiI2ZmZiJ9fX0=)
](https://d3bkbkx82g74b8.cloudfront.net/eyJidWNrZXQiOiJsYWJyb290cy1pbWFnZXMiLCJrZXkiOiJjb21wYW55X3Byb2R1Y3RfcHJvZmlsZV9pbWFnZV80NWQwMTQwMmZjN2M2ODZjMGIxN2FlZDVkMGNlNzM0YmJkMTVmZTg1XzI3ODgwNTM4NzY4LmpwZyIsImVkaXRzIjp7InRvRm9ybWF0IjoianBnIiwicmVzaXplIjp7IndpZHRoIjozMDAsImhlaWdodCI6MzAwLCJmaXQiOiJjb250YWluIiwicG9zaXRpb24iOiJjZW50ZXIiLCJiYWNrZ3JvdW5kIjoiI2ZmZiJ9LCJmbGF0dGVuIjp7ImJhY2tncm91bmQiOiIjZmZmIn19fQ==)
![Anti-PAX8 antibody [SP348] - N-terminal](https://d3bkbkx82g74b8.cloudfront.net/eyJidWNrZXQiOiJsYWJyb290cy1pbWFnZXMiLCJrZXkiOiJjb21wYW55X3Byb2R1Y3RfcHJvZmlsZV9pbWFnZV9jYWIzMjc3Mjc2N2MzNmY1ZjRjYjAzMzU4ZjkwN2YyNWE0ZWM0ZGUxXzI3NTIyODQzMzEuanBnIiwiZWRpdHMiOnsidG9Gb3JtYXQiOiJqcGciLCJyZXNpemUiOnsid2lkdGgiOjMwMCwiaGVpZ2h0IjozMDAsImZpdCI6ImNvbnRhaW4iLCJwb3NpdGlvbiI6ImNlbnRlciIsImJhY2tncm91bmQiOiIjZmZmIn0sImZsYXR0ZW4iOnsiYmFja2dyb3VuZCI6IiNmZmYifX19)
![Anti-DFNA5/GSDME antibody [EPR19859] - N-terminal](https://d3bkbkx82g74b8.cloudfront.net/eyJidWNrZXQiOiJsYWJyb290cy1pbWFnZXMiLCJrZXkiOiJjb21wYW55X3Byb2R1Y3RfcHJvZmlsZV9pbWFnZV8zMDc3NzdjNGVmOTM0YTA5ZmYwY2E4MzgyZmNlNDUyNjYwNjQyYmUyXzUzNzYyODQyNDI5LmpwZyIsImVkaXRzIjp7InRvRm9ybWF0IjoianBnIiwicmVzaXplIjp7IndpZHRoIjozMDAsImhlaWdodCI6MzAwLCJmaXQiOiJjb250YWluIiwicG9zaXRpb24iOiJjZW50ZXIiLCJiYWNrZ3JvdW5kIjoiI2ZmZiJ9LCJmbGF0dGVuIjp7ImJhY2tncm91bmQiOiIjZmZmIn19fQ==)
](https://d3bkbkx82g74b8.cloudfront.net/eyJidWNrZXQiOiJsYWJyb290cy1pbWFnZXMiLCJrZXkiOiJjb21wYW55X3Byb2R1Y3RfcHJvZmlsZV9pbWFnZV8zMjEzY2IyMTViZDRmZTUyMGI2ZWQ0M2RhNjE4YTRiYjk3YmFmNzRmXzgzNjg0MjkzMTE1LmpwZyIsImVkaXRzIjp7InRvRm9ybWF0IjoianBnIiwicmVzaXplIjp7IndpZHRoIjozMDAsImhlaWdodCI6MzAwLCJmaXQiOiJjb250YWluIiwicG9zaXRpb24iOiJjZW50ZXIiLCJiYWNrZ3JvdW5kIjoiI2ZmZiJ9LCJmbGF0dGVuIjp7ImJhY2tncm91bmQiOiIjZmZmIn19fQ==)

![Anti-DDDDK tag (Binds to FLAG® tag sequence) antibody [EPR20018-251]](https://d3bkbkx82g74b8.cloudfront.net/eyJidWNrZXQiOiJsYWJyb290cy1pbWFnZXMiLCJrZXkiOiJjb21wYW55X3Byb2R1Y3RfcHJvZmlsZV9pbWFnZV84NmE5YzJiNGNkNGQxMjI4NTgwOTBiNzc0MWIzMjRkMzllYjY4ZmE1XzE2MDU5NTQ3MjE3LmpwZyIsImVkaXRzIjp7InRvRm9ybWF0IjoianBnIiwicmVzaXplIjp7IndpZHRoIjozMDAsImhlaWdodCI6MzAwLCJmaXQiOiJjb250YWluIiwicG9zaXRpb24iOiJjZW50ZXIiLCJiYWNrZ3JvdW5kIjoiI2ZmZiJ9LCJmbGF0dGVuIjp7ImJhY2tncm91bmQiOiIjZmZmIn19fQ==)
](https://d3bkbkx82g74b8.cloudfront.net/eyJidWNrZXQiOiJsYWJyb290cy1pbWFnZXMiLCJrZXkiOiJjb21wYW55X3Byb2R1Y3RfcHJvZmlsZV9pbWFnZV81MzY2YmRkNDZkOTkxNGFlMzA1NTk1MjE3ZWI1ZTI3YWJjMGE2MWY3XzM4MzkwMjY2MzUzLmpwZyIsImVkaXRzIjp7InRvRm9ybWF0IjoianBnIiwicmVzaXplIjp7IndpZHRoIjozMDAsImhlaWdodCI6MzAwLCJmaXQiOiJjb250YWluIiwicG9zaXRpb24iOiJjZW50ZXIiLCJiYWNrZ3JvdW5kIjoiI2ZmZiJ9LCJmbGF0dGVuIjp7ImJhY2tncm91bmQiOiIjZmZmIn19fQ==)
![Anti-GFAP antibody [EPR1034Y]](https://d3bkbkx82g74b8.cloudfront.net/eyJidWNrZXQiOiJsYWJyb290cy1pbWFnZXMiLCJrZXkiOiJjb21wYW55X3Byb2R1Y3RfcHJvZmlsZV9pbWFnZV8wZjJjNzQzZWVjMDgyMWMyNTJiMzJiOTAwZjJiYjE3ZTgzNzk0OWZkXzQxODczMjEzNjAyLnBuZyIsImVkaXRzIjp7InRvRm9ybWF0IjoianBnIiwicmVzaXplIjp7IndpZHRoIjozMDAsImhlaWdodCI6MzAwLCJmaXQiOiJjb250YWluIiwicG9zaXRpb24iOiJjZW50ZXIiLCJiYWNrZ3JvdW5kIjoiI2ZmZiJ9LCJmbGF0dGVuIjp7ImJhY2tncm91bmQiOiIjZmZmIn19fQ==)







































